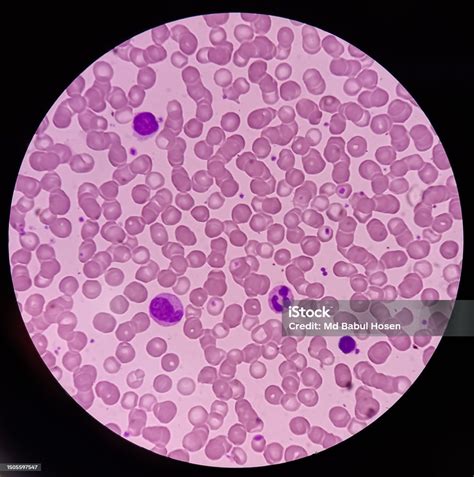
Microfotografía de células inmunitarias (leucocitos) mostrando su migración.

El ser humano es un organismo homeotermo, lo que significa que posee la capacidad de regular su metabolismo para mantener una temperatura interna constante. Sin embargo, cuando la temperatura corporal aumenta, las funciones fisiológicas normales se ven comprometidas, y el sistema termorregulador puede volverse insuficiente.
Los efectos de las altas temperaturas dependen de su intensidad, duración y del nivel de aclimatación del individuo. La adaptación a las variaciones de temperatura ambiental es un proceso gradual que puede requerir desde varios días hasta semanas.
Efectos Directos de la Exposición al Calor
La exposición prolongada a altas temperaturas puede desencadenar una serie de efectos directos en el organismo, que incluyen:
- Agotamiento por calor: Fatiga y debilidad generalizada.
- Calambres: Contracciones musculares involuntarias.
- Síncopes o lipotimias: Pérdida temporal del conocimiento debido a una perfusión cerebral insuficiente.
- Dermatitis: Irritaciones cutáneas.
- Edemas de extremidades: Hinchazón en brazos y piernas.
- Golpe de calor: Una emergencia médica grave.
La vasodilatación cutánea, un mecanismo de adaptación al calor que aumenta el flujo sanguíneo a la piel para disipar calor, junto con la pérdida de fluidos y la disminución del gasto cardíaco, pueden llevar a un retorno venoso central inadecuado y una perfusión cerebral insuficiente. Esto provoca el síncope o lipotimia, que suele ocurrir tras permanecer mucho tiempo de pie en días calurosos y se caracteriza por ser un cuadro autolimitado y de corta duración. Las medidas posturales, como tumbar a la persona a la sombra con las piernas elevadas, pueden ayudar.

Golpe de Calor: Una Urgencia Médica
El golpe de calor es el cuadro más grave derivado de la exposición al calor. Se origina por el fracaso agudo de la regulación de la temperatura corporal, que puede superar rápidamente los 40°C. Su aparición es muy rápida, en cuestión de horas, y constituye una urgencia médica que requiere ayuda inmediata.
Es fundamental llamar a los servicios de emergencia de inmediato. Las primeras acciones incluyen quitar la ropa, mojar constantemente la piel para bajar la temperatura, y aplicar compresas o toallas frías en axilas, ingles, cuello y cabeza. Rociar la piel con agua o utilizar cualquier medio disponible para enfriar al afectado es crucial.
Impacto del Calor en Patologías Preexistentes
El calor puede agravar condiciones médicas preexistentes:
- Patologías respiratorias: El calor incrementa la demanda de oxígeno a nivel celular, lo cual puede ser insostenible para personas con insuficiencia respiratoria.
- Patologías cardiovasculares: La deshidratación provoca hemoconcentración y un aumento en la viscosidad de la sangre, incrementando el riesgo de trombos, accidentes cerebrovasculares y coronarios.
Grupos Vulnerables y Medidas de Prevención
La tolerancia al calor varía significativamente entre individuos. Ciertos grupos son particularmente vulnerables a los efectos de las altas temperaturas:
- Lactantes y niños de corta edad: Sus mecanismos de regulación térmica son inmaduros.
- Embarazadas: Requieren precauciones adicionales.
- Personas mayores: Sus sistemas de termorregulación pueden ser menos eficientes.
- Enfermos crónicos: Patologías preexistentes pueden verse agravadas.
- Personas no aclimatadas: Especialmente al inicio de la época estival o ante olas de calor.
Para prevenir los efectos adversos del calor, se recomienda:
- Limitar actividades intensas al aire libre, especialmente en las horas centrales del día.
- Permanecer en las zonas más frescas del hogar.
- Usar ropa amplia, ligera y de color claro.
- Evitar permanecer en coches parados sin aire acondicionado, incluso con las ventanillas abiertas.
- Nunca dejar solos a niños, ancianos, enfermos crónicos o mascotas en un vehículo.
- Beber frecuentemente, sin esperar a tener sed, prestando especial atención a la hidratación de los grupos vulnerables.
- Limitar el consumo de cafeína y bebidas azucaradas.
- Realizar comidas ligeras.
- Consultar al médico o farmacéutico sobre medidas complementarias si se toman medicamentos o se padece alguna patología crónica.

Regulación de la Temperatura y Respuestas Celulares
Los cambios de temperatura influyen en los procesos biológicos a todas las escalas, desde las reacciones moleculares hasta la fisiología del organismo completo. La homeostasis es el estado de equilibrio interno que los organismos buscan mantener para su supervivencia, independientemente de las fluctuaciones ambientales.
Cuando los mecanismos homeostáticos fallan en mantener los valores óptimos, surgen las enfermedades. La homeostasis puede ser sistémica (del organismo completo) o celular, refiriéndose a las condiciones internas que permiten a la célula funcionar de manera óptima.
Respuesta al Estrés Celular
Salir de la zona de confort celular, es decir, rebasar los límites de los parámetros homeostáticos, desencadena la respuesta al estrés celular. Esta respuesta involucra mecanismos moleculares para contrarrestar las alteraciones y sus consecuencias. Los estímulos estresantes pueden ser externos (falta de nutrientes, temperatura extrema, toxinas, hipoxia) o internos.
La respuesta al estrés se compone de tres categorías:
- Sensores: Moléculas que detectan daños o cambios en parámetros como la temperatura, el nivel de oxígeno o el estado energético.
- Cascada de señalización: Vías moleculares (a menudo involucrando quinasas y factores de transcripción) que transmiten la señal de estrés.
- Efectores: Mecanismos que promueven la supervivencia celular (reparación de ADN, autofagia, síntesis de proteínas de choque térmico) o, si el estrés es severo, inducen muerte celular programada (apoptosis) o senescencia.

Proteínas de Choque Térmico (HSP)
Las proteínas de choque térmico (HSP), también conocidas como proteínas de estrés, se sintetizan en respuesta a diversas formas de estrés, no solo al aumento de temperatura. Ayudan a mantener la proteostasis (homeostasis proteica) mediante:
- Asistencia en el plegamiento correcto de las proteínas.
- Desagregación de complejos proteicos tóxicos.
- Reubicación de proteínas a través de membranas.
- Marcaje de proteínas para su degradación.
- Inhibición de la apoptosis.
Estas proteínas, agrupadas en familias (grandes y pequeñas), son esenciales para la supervivencia celular y se encuentran en todos los compartimentos celulares.
Respuesta al Daño del ADN
El ADN es susceptible a daños constantes por factores internos y externos. La respuesta al daño del ADN activa puntos de control del ciclo celular, deteniendo su progresión para permitir la reparación. Si el daño es irreparable, se activan mecanismos de senescencia o apoptosis.
La molécula p53 juega un papel crucial en esta respuesta, determinando si la célula detiene su ciclo, entra en senescencia o se autodestruye.
Retículo Endoplasmático y Estrés
El retículo endoplasmático participa en la síntesis y el plegamiento de proteínas. El estrés en el retículo endoplasmático (ER stress) ocurre cuando hay un desequilibrio entre la carga de proteínas y la capacidad de plegamiento, lo que lleva a la acumulación de proteínas mal plegadas. El sistema ERAD (Endoplasmic-reticulum-associated protein degradation) intenta eliminar estas proteínas, pero si falla, pueden desencadenarse respuestas celulares adversas.
Impacto del Calor en Sistemas Biológicos Específicos
Células Inmunitarias y Temperatura
Investigaciones recientes han demostrado que la temperatura regula la velocidad y la eficacia de las células inmunitarias. Cambios de temperatura similares a la fiebre aceleran la migración de leucocitos (como linfocitos T, macrófagos, células dendríticas y neutrófilos) hacia las heridas y los vasos linfáticos. La proteína motora miosina II ha sido identificada como un mediador clave en estas termorrespuestas celulares rápidas y reversibles.
Calor Extremo y Envejecimiento Biológico
La evidencia científica sugiere que la exposición crónica al calor extremo puede acelerar el envejecimiento biológico. Estudios han encontrado que personas que viven en zonas de calor extremo tienen edades biológicas hasta 14 meses mayores que aquellas en regiones más frías. Los mecanismos subyacentes incluyen:
- Estrés cardiovascular: El corazón trabaja más para disipar calor.
- Sobrestimulación del sistema nervioso: Puede causar mareos y confusión.
- Mayor esfuerzo renal: Para conservar agua, aumentando el riesgo de deshidratación.
- Inflamación crónica: Liberación de sustancias inflamatorias por el sistema inmunitario.
- Daño oxidativo y alteraciones hormonales: Que pueden modificar la expresión génica.
- Envejecimiento epigenético: Cambios en la metilación del ADN que afectan la regulación genética.
Estos efectos pueden desgastar sistemas clave y acelerar el deterioro relacionado con la edad, aumentando el riesgo de enfermedades crónicas. Las estrategias de prevención incluyen el uso de aire acondicionado, evitar la exposición directa al sol en horas pico, mantenerse hidratado y fortalecer las redes de apoyo social.
Efectos del calor en la salud
Efectos en el Hueso y la Consolidación
Estudios en conejos han investigado el efecto de la hipertermia hídrica controlada en la consolidación ósea. La exposición a temperaturas elevadas (por encima de 60°C durante 20 minutos) mostró diferencias significativas en la concentración de elementos químicos (potasio, magnesio, azufre y fósforo) y un retardo en la consolidación ósea, indicando una alteración metabólica y morfológica.
Impacto del Calor en Otros Organismos y Procesos
Grasa Parda y Crecimiento Tumoral
La grasa parda, un tejido que genera calor en respuesta al frío, puede tener un papel en la supresión del crecimiento tumoral. En ratones, la exposición al frío activó la grasa parda, la cual acaparó glucosa, un nutriente esencial para las células cancerosas. Esto resultó en una inhibición significativa del crecimiento tumoral y un aumento en la supervivencia de los animales. Este efecto fue reversible al aumentar la temperatura.
Rigor Mortis en Pescado y Temperatura
La temperatura influye en el proceso de rigor mortis en el pescado. Generalmente, temperaturas más altas aceleran el inicio y la duración del rigor. Sin embargo, en algunas especies tropicales se ha observado el efecto opuesto. El rigor mortis afecta la textura y la calidad del pescado, impactando el rendimiento del fileteado y las características organolépticas del producto cocido.
La disminución del pH en el músculo post mortem, causada por la acumulación de ácido láctico durante la glucólisis anaeróbica, también tiene un efecto en las propiedades físicas del músculo, reduciendo su capacidad de retener agua.
